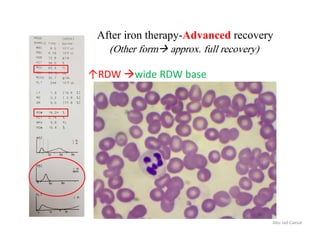
After iron therapy-Advanced recovery
(Other form approx. full recovery)
Abu Jad Caesar
↑RDW wide RDW base

Embed presentation
Download as PDF, PPTX















































This document discusses RBC histogram patterns seen in various hematological conditions and treatments. It notes that thalassemia major patients will show abnormalities in WBC, RBC and PLT counts. Advanced iron deficiency is characterized by an extremely wide RDW base. After iron therapy, early recovery shows a very wide RDW base that narrows with advanced recovery. Blood transfusions can result in a dimorphic pattern with a very wide RDW base. Incubation of samples at 37 degrees C can reveal RBC fragmentation.